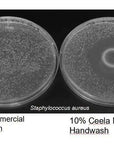
Revitalizing Hand Wash Your Natural Ally for Healthy Hands Ceela Naturals

CLA Hand Wash – Powerful Cleanse That Nourishes & Strengthens Hands
Water, Potassium Linoleate (CLA from Safflower), Pro-Vit B5 (Panthenol), Alanine, Arginine, Aspartate, Isoleucine
What is Conjugated Linoleic Acid (CLA)?
Conjugated Linoleic Acid (CLA), is sometimes called Isomerized Linoleic Acid. Same molecule, same benefits.
Our CLA is derived from non-GMO safflower oil and gently converted into a skin-friendly potassium salt. It’s the exact same natural compound your body already recognizes and uses every day — in fact, most people consume 200–300 times more CLA through normal diet (beef, dairy, safflower oil) than what’s in our topical formulas.
Millions safely supplement CLA orally — even during pregnancy — because it’s classified as food-grade and GRAS (Generally Recognized as Safe).
At Ceela, we simply harness this trusted, edible powerhouse to calm inflammation, strengthen skin barriers, and restore microbiome harmony — from the outside in.
* FDA Disclaimer: Statements on this website have not been evaluated by the Food and Drug Administration. Ceela Naturals products are not intended to diagnose, treat, cure, or prevent any disease.